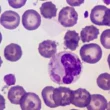

جدول المحتويات
- ما هو اليوريك أسيد؟
- أسباب ارتفاع اليوريك أسيد
- أعراض ارتفاع اليوريك أسيد
- الأطعمة التي تحتوي على اليوريك أسيد
- علاج ارتفاع اليوريك أسيد
- نصائح للوقاية من ارتفاع اليوريك أسيد
ما هو اليوريك أسيد؟
اليوريك أسيد هو مركب كيميائي ينتج في الجسم نتيجة تحطيم مركبات البيورين، وهي مواد موجودة في بعض الأطعمة وخلايا الجسم. يتم إخراج معظم اليوريك أسيد عن طريق البول، ولكن عندما يزداد إنتاجه أو تقل قدرة الكلى على التخلص منه، يتراكم في الدم مسبباً ارتفاعاً في مستوياته.
المعدل الطبيعي لليوريك أسيد في الدم يتراوح بين 2.4 إلى 6 مليجرام/ديسيلتر للنساء، و3.4 إلى 7 مليجرام/ديسيلتر للرجال. قد تختلف هذه النسب قليلاً بين المختبرات الطبية.
أسباب ارتفاع اليوريك أسيد
يمكن أن يرتفع اليوريك أسيد في الدم نتيجة عدة عوامل، منها:
- الارتفاع الأولي: يحدث بسبب زيادة إنتاج البيورين في الجسم أو عدم قدرة الكلى على إخراج اليوريك أسيد بشكل كافٍ.
- الارتفاع الثانوي: قد يكون نتيجة تناول بعض الأدوية مثل مدرات البول أو فيتامين B-3، أو بسبب أمراض الكلى التي تعيق وظيفتها.
- أمراض أخرى: مثل قصور الغدة الدرقية، الصدفية، أو متلازمة انحلال الورم.
أعراض ارتفاع اليوريك أسيد
في كثير من الحالات، لا تظهر أعراض واضحة لارتفاع اليوريك أسيد. ومع ذلك، عند زيادة مستوياته بشكل كبير، قد يؤدي إلى مشاكل صحية مثل:
- النقرس: يسبب ألماً شديداً وتورماً في المفاصل، خاصة في إصبع القدم الكبير.
- حصى الكلى: قد تسبب ألماً حاداً في البطن، دم في البول، أو ألم عند التبول.
- الفشل الكلوي: من أخطر المضاعفات، ويصاحبه صعوبة في التنفس، انخفاض معدل التبول، ودوخة.
الأطعمة التي تحتوي على اليوريك أسيد
تناول الأطعمة الغنية بالبيورين يمكن أن يزيد من إنتاج اليوريك أسيد في الجسم. ومن هذه الأطعمة:
- الخميرة ومنتجاتها مثل البيرة.
- السبانخ، الفاصولياء، والبازلاء.
- العدس، الشوفان، والقرنبيط.
من ناحية أخرى، يُنصح بتناول الأطعمة قليلة البيورين مثل الحليب، الخضروات الخضراء، والفواكه.
علاج ارتفاع اليوريك أسيد
يشمل علاج ارتفاع اليوريك أسيد عدة خطوات، منها:
- تجنب الأطعمة الغنية بالبيورين.
- الابتعاد عن الكحول والكافيين.
- تناول الأدوية التي تقلل إنتاج اليوريك أسيد أو تساعد في إخراجه، مثل ألوبيورينول.
نصائح للوقاية من ارتفاع اليوريك أسيد
للوقاية من ارتفاع اليوريك أسيد، يمكن اتباع النصائح التالية:
- شرب كميات كافية من الماء يومياً.
- ممارسة الرياضة بانتظام.
- تجنب الأطعمة والمشروبات التي تزيد من إنتاج اليوريك أسيد.
يجب استشارة الطبيب في حالة ظهور أي أعراض أو عند وجود تاريخ مرضي يتعلق بارتفاع اليوريك أسيد.